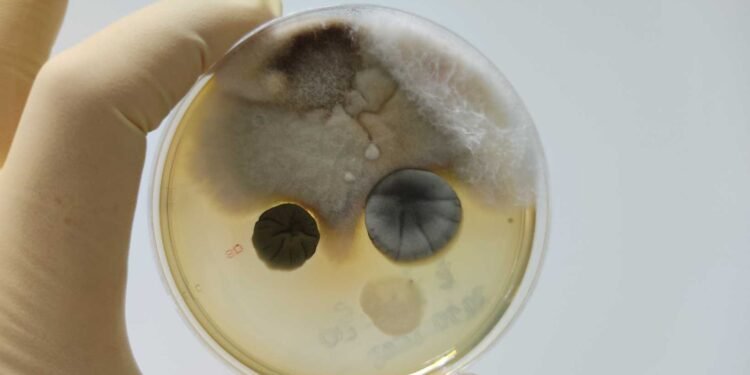
Understanding the Limitations of Home Mold Test Kits: What You Need to Know

Home mold test kits are designed to provide homeowners with a quick and easy way to test for mold in their homes. These kits are often marketed as an affordable alternative to professional mold inspections. However, it is important to understand the limitations of these kits in order to make informed decisions about their use.

Mold can have serious health implications, and it is important to take steps to prevent its growth in the home. Home mold test kits can provide a preliminary indication of the presence of mold, but they are not always accurate or comprehensive. In some cases, they may even provide false negatives, leading homeowners to believe that their homes are free of mold when they are not.
To truly understand the limitations of home mold test kits, it is important to have a basic understanding of mold and the health risks associated with it. With this knowledge, homeowners can make informed decisions about whether to use a home mold test kit, and how to interpret the results. By evaluating the effectiveness of these kits, and understanding the benefits of professional mold inspections, homeowners can take proactive steps to protect their health and their homes.
Key Takeaways
- Home mold test kits can provide a preliminary indication of mold, but they are not always accurate or comprehensive.
- Professional mold inspections are more effective at identifying and addressing mold issues.
- Understanding the limitations of home mold test kits is crucial for making informed decisions about mold prevention and remediation.
The Basics of Mold and Health Risks

Mold is a type of fungus that grows in damp and humid environments. It can grow on a variety of surfaces, including walls, carpets, and furniture. Mold spores can spread through the air and cause health problems for people who are sensitive to them.
Types of Mold and Their Effects
There are many different types of mold, and each can have different effects on people. Some molds are harmless, while others can be toxic. One of the most dangerous types of mold is black mold, which can cause serious respiratory issues and other health problems.
Health Problems Associated with Mold Exposure
Exposure to mold can cause a range of health problems, including allergies, respiratory issues, and other health problems. People who are allergic to mold may experience symptoms such as sneezing, runny nose, and itchy eyes. In some cases, exposure to mold can cause more serious health problems, such as asthma attacks or infections in the lungs.
It’s important to understand the health risks associated with mold exposure and take steps to prevent it from growing in your home. While home mold test kits can be useful for identifying mold, it’s important to understand their limitations and seek professional help if necessary.
Understanding Home Mold Test Kits
Home mold test kits are a popular way for homeowners to check for mold in their homes. These kits typically include sampling materials and instructions for collecting samples, which are then sent to a laboratory for analysis. The exact contents of home mold test kits can vary, but they often include the following components:
Components of a Typical Mold Test Kit
- Swabs: These are used to collect samples from surfaces that may have mold growth, such as walls or ceilings.
- Petri dishes: These are used to collect air samples. The dish is left open for a set amount of time to allow air to settle in the dish, and then it is closed and sent to a lab for analysis.
- Tape strips: These are used to collect samples from surfaces that may have mold growth, such as walls or ceilings.
Different Testing Methods
There are two main types of mold testing methods: air testing and surface testing. Air testing is used to determine the concentration of mold spores in the air, while surface testing is used to determine the presence of mold on surfaces.
Home mold test kits typically use surface testing methods, as they are easier to perform and do not require expensive equipment. However, surface testing has its limitations, as it only detects the presence of mold on surfaces and does not provide information about the concentration of mold spores in the air.
It is important to note that home mold test kits have their limitations and may not always be accurate. Homeowners should carefully follow the instructions provided with the kit to ensure that the samples are collected properly. Additionally, it is recommended that homeowners send their samples to a reputable laboratory for analysis to ensure accurate results.
Overall, while home mold test kits can be a useful tool for detecting mold in the home, they should not be relied upon as the sole means of determining the presence of mold. Homeowners should also be aware of the limitations of these kits and consider seeking professional mold testing services if they suspect a mold problem in their home.
Evaluating Mold Test Kit Effectiveness
Accuracy of Results
Home mold test kits are a popular option for homeowners who suspect mold growth in their homes. However, it is important to understand the limitations of these kits to make informed decisions about mold testing and remediation. One of the primary concerns with home mold test kits is the accuracy of their results.
According to a study published in the Journal of Occupational and Environmental Medicine, over 80% of home mold test kits produce inaccurate results. The study found that these kits often produce false positives and false negatives, which can lead to unnecessary remediation or the failure to address a mold problem.
It is important to note that some home mold test kits are more accurate than others. For example, the Health Metric Mold Test Kit includes testing fees for up to three samples and provides professional lab evaluation, which can provide more accurate and detailed results.
Limitations of DIY Testing
Another limitation of home mold test kits is the fact that they are DIY testing methods. As such, they are subject to user error and may not provide an overall understanding of the mold contamination. For instance, not following the instructions properly or failing to take samples from the right areas can lead to misinterpretation of results.
Moreover, home mold test kits may not account for dead spores, which can also impact the health of homeowners. Water damage-makers such as Stachybotys, Chaetomium, and Ulocladium may not show up on the DIY kit.
Therefore, it is recommended that homeowners seek professional mold testing and remediation services for accurate and reliable results. Professional mold testing companies have the expertise and equipment necessary to identify and address mold problems effectively.
Professional Mold Inspection vs. DIY Kits
Homeowners who suspect mold growth in their homes may turn to DIY mold test kits as a cost-effective and convenient solution to detect the presence of mold. However, these kits may not always provide reliable results. Professional mold inspections, on the other hand, offer a more accurate assessment of mold contamination in a home.
When to Seek Professional Testing
In some cases, it may be necessary to seek professional mold testing. For example, if a homeowner suspects a significant mold problem, or if they have experienced health issues related to mold exposure, they should contact a professional mold inspector. Professional mold inspections can provide a comprehensive view of the extent of the mold problem and the type of mold present.
Comparing Costs and Benefits
While DIY mold test kits offer a cost-effective option, they may not provide the same level of accuracy and reliability as a professional mold inspection. Professional inspectors bring expertise, specialized equipment, and the ability to assess hidden areas, providing a more comprehensive view of the mold problem. The cost of a professional mold inspection may vary depending on the size of the home, the extent of the mold problem, and the location. However, the benefits of hiring a professional mold inspector may outweigh the costs in terms of accurate results and peace of mind.
In summary, while DIY mold test kits may be a convenient and affordable option, they may not always provide reliable results. Homeowners who suspect mold growth in their homes should consider seeking professional mold testing for a more accurate assessment of mold contamination.
Interpreting Test Results

After conducting a home mold test, it is important to understand how to interpret the results accurately. This section will explain the steps to take after receiving the results of a home mold test.
Understanding Lab Analysis
Most home mold test kits come with instructions on how to collect samples and send them to a lab for analysis. It is crucial to choose a reputable and certified lab to ensure accurate results. Once the samples are analyzed, the lab will provide a detailed report of the mold types and quantities found in the samples.
It is important to note that home mold test kits have limitations, and the results should be interpreted with caution. According to GreenWorks Environmental LLC, “Mold testing alone is not enough to determine if there is a mold problem in your home. You also need to assess the conditions that promote mold growth and take steps to correct them.
Actionable Steps After Testing
If the results of a home mold test indicate the presence of mold, it is important to take immediate action to remediate the problem. The first step is to identify the source of the mold and fix the underlying issue. For example, if the mold is caused by a leaky pipe, the pipe should be repaired or replaced to prevent further mold growth.
Once the source of the mold has been addressed, it is important to clean and remove the mold properly. The Environmental Protection Agency (EPA) recommends using a solution of detergent and water to clean mold from non-porous surfaces. For porous surfaces, such as drywall or carpeting, it may be necessary to replace the affected materials.
It is important to note that some types of mold can be hazardous to health, and professional remediation may be necessary. If the mold covers an area larger than 10 square feet, or if the mold is caused by sewage or contaminated water, it is recommended to seek professional help.
In conclusion, interpreting the results of a home mold test requires careful consideration of the lab analysis and taking appropriate steps for remediation. It is important to understand the limitations of home mold test kits and seek professional help if necessary.
Strategies for Mold Remediation

Mold remediation is the process of removing mold from a building and preventing its future growth. Effective mold remediation requires a combination of techniques to ensure that all mold is removed and that it does not return.
Effective Remediation Techniques
Effective mold remediation techniques include:
-
Source Removal: The most effective way to remove mold is to physically remove it. This involves removing any materials that contain mold, such as drywall, carpet, or insulation. It is important to ensure that all mold is removed, as even a small amount can grow and spread.
-
Encapsulation: Encapsulation involves sealing mold with a special coating that prevents it from growing or spreading. This technique is often used when mold cannot be physically removed, such as in cases where it is growing inside walls or other inaccessible areas.
-
Air Filtration: Air filtration involves using special filters to remove mold spores from the air. This technique is often used in conjunction with other remediation techniques to ensure that all mold is removed.
Preventing Future Mold Growth
Preventing future mold growth is an important part of mold remediation. Here are some strategies for preventing mold growth:
-
Controlling Moisture: Mold thrives in moist environments, so controlling moisture is key to preventing its growth. This can be done by fixing leaks, using dehumidifiers, and ensuring that there is adequate ventilation in the building.
-
Regular Inspections: Regular inspections can help identify mold growth before it becomes a problem. It is important to inspect areas that are prone to moisture, such as bathrooms, kitchens, and basements.
-
Proper Ventilation: Proper ventilation can help prevent mold growth by ensuring that moisture is not trapped inside the building. This can be done by opening windows, using exhaust fans, and ensuring that HVAC systems are properly maintained.
By using these effective mold remediation techniques and preventing future mold growth, homeowners can ensure that their homes are safe and healthy environments.
Selecting the Right Mold Test Kit

When it comes to selecting the right mold test kit, it is crucial to consider various factors to ensure accurate results. The market is flooded with different types of home mold test kits, making it challenging to choose the right one. This section will provide a brief overview of the factors to consider before purchasing a mold test kit and the top picks and reviews.
Top Picks and Reviews
There are several top-rated mold test kits available in the market. According to Bob Vila, the best mold test kit for 2023 is the Healthful Home 5-Minute Mold Test. This kit is easy to use and provides accurate results in just five minutes. Another top pick is the Seeml Labs DIY Mold Test Kit, which is affordable and provides results from an AIHA-accredited lab. The Mold Armor Do It Yourself Mold Test Kit is another budget-friendly option that provides quick and accurate results.
Factors to Consider Before Purchasing
Before purchasing a mold test kit, it is essential to consider the following factors:
-
Type of mold: Some mold test kits can identify specific species of mold, while others may only provide an indication of the presence of mold without identifying the specific type. It is crucial to choose the right mold test kit for your specific needs.
-
Testing method: Different mold test kits use different testing methods, such as swabbing, tape lifting, or air sampling. It is essential to choose the testing method that is most appropriate for your situation.
-
Accuracy: The accuracy of the mold test kit is critical to ensure that you are getting reliable results. It is crucial to choose a mold test kit that is known for its accuracy.
-
Price: The price of the mold test kit is also an important consideration. While some kits may be more expensive, they may offer more accurate results. It is essential to balance accuracy with price to choose the best mold test kit for your needs.
In conclusion, selecting the right mold test kit is crucial to ensure accurate results. By considering the factors mentioned above and reviewing the top picks and reviews, you can make an informed decision and choose the best mold test kit for your needs.
Frequently Asked Questions
How accurate are home mold test kits compared to professional assessments?
Home mold test kits can provide a preliminary assessment of mold presence in a residential property. However, it is important to note that these kits may not be as accurate as professional assessments. Professional mold inspectors are trained to conduct comprehensive testing, including air and surface sampling, and interpret the results accurately. Home mold test kits may not provide a comprehensive assessment of mold presence, and their accuracy may be affected by various factors, including user error, sample collection, and laboratory analysis.
What are the common causes of false positives in home mold testing?
False positives can occur in home mold testing due to various factors, including sample contamination, user error, and the presence of non-mold substances that can trigger the test. For example, dust, pollen, and other organic materials can sometimes be mistaken for mold. It is important to follow the instructions provided with the home mold test kit carefully to minimize the risk of false positives.
Can home mold test kits differentiate between harmless and harmful mold types?
Home mold test kits can identify the presence of mold, but they may not be able to differentiate between harmless and harmful mold types. Some types of mold, such as black mold, can be toxic and pose health risks. It is important to consult a professional mold inspector if you suspect the presence of harmful mold in your home.
What should be considered when interpreting the results of a home mold test kit?
When interpreting the results of a home mold test kit, it is important to consider the type of mold detected, the concentration of mold spores, and the location of the mold. It is also important to consider any symptoms of mold exposure, such as respiratory issues or allergies. If the test indicates the presence of mold, it is recommended to consult a professional mold inspector for a comprehensive assessment.
How often should one conduct mold testing in a residential property?
The frequency of mold testing in a residential property depends on various factors, including the age of the property, the presence of moisture, and any history of mold issues. It is recommended to conduct mold testing annually or whenever there is a suspected mold issue.
What are the next steps if a home mold test kit indicates the presence of mold?
If a home mold test kit indicates the presence of mold, it is important to take immediate action to address the issue. This may include consulting a professional mold inspector, identifying and fixing any sources of moisture, and cleaning and disinfecting the affected areas. It is important to follow proper safety precautions, such as wearing protective gear, when handling mold.